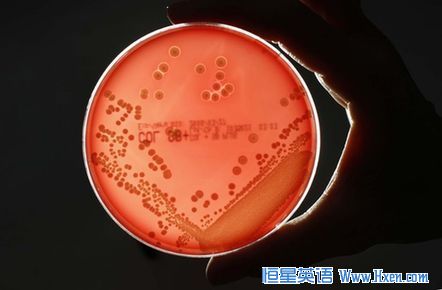

近日,在南亚等地出现了一种超级病菌。据报道,这种新型病菌可以通过饮水等途径传播,引发肠道感染等病症,而且对几乎所有抗生素都具有抗药性。英国医学周刊日前发布研究报告称,这种病菌发源于印度,并用印度首都新德里为前缀为该病菌命名。印度政府对此表示愤怒,宣称这是针对该国正在起步的医疗旅游业的阴谋。印度卫生部在一份声明中说,西方一些媒体仅根据不完整的病例报告就把这种不明原因的病菌与印度联系起来,这是非常错误和不公正的。印度尤其反对用印度首都新德里的名字来命名这种病菌。声明说,印度的医疗机构一向为前来印度进行医疗旅游的外国游客提供良好的治疗和护理条件,目前印度完全没有受到这种新出现的病菌的威胁,在印度旅行以及在印度的医院进行治疗都是绝对安全的。
India has reacted angrily to a medical study linking Indian hospitals to a multi-resistant "superbug," with some politicians claiming a conspiracy against the country's booming medical tourism industry.
The study, published in the British medical journal The Lancet, said health tourists flocking to South Asia had carried a new class of antibiotic-resistant superbug to Britain, and warned that it could spread worldwide.
In a strong statement issued late Thursday, the Indian health ministry criticized the report for scaremongering and took particular exception to the naming of the NDM-1 bacteria -- or "New Delhi metallo-lactamase-1".
The ministry acknowledged that such bacteria might circulate more widely with advances in international travel.
"But to link this with the safety of surgery in hospitals in India and citing isolated examples to show that... India is not a safe place to visit, is wrong," the statement said.
"We strongly refute the naming of the enzyme... and also refute that hospitals in India are not safe for treatment including medical tourism."
The NDM-1 gene was first identified last year by Cardiff University's Timothy Walsh in two types of bacteria -- Klebsiella pneumoniae and Escherichia coli -- in a Swedish patient admitted to hospital in India.
Worryingly, the new NDM-1-carrying bacteria are resistant even to carbapenems, a group of antibiotics often reserved as a last resort for emergency treatment for multi-drug resistant bugs.
Researchers said the bugs had been brought into Britain by patients who travelled to India or Pakistan for cosmetic surgery.
South Asia, and India in particular, is undergoing a medical tourism boom, with swanky new hospitals and well-trained medical staff offering everything from facelifts to fertility treatments and open-heart surgery at half the price of western Europe.
The Lancet study was mentioned in India's parliament with some angry MPs denouncing what they saw as a plot by global pharmaceutical firms.
"When India is emerging as a medical tourism destination, this type of news is unfortunate and may be a sinister design of multi-national companies," said Hindu-nationalist MP SS Ahluwalia.
India has been criticized in the past for having a loose policy on antibiotics use, with the result that they are over-prescribed and over-used to the point where resistant strains become more common.
V.M. Katoch, director general of the Indian Council of Medical Research, told AFP that multiple drug resistance was "always a concern".
"But when you draw conclusions that link it to a specific country, then you are going too far," Katoch said.
"When you link it to our antibiotics policy... say it is dangerous to get operated on in India and that you will get more infections, that is totally irrational."
In the new study, led by Walsh and Chennai University's Karthikeyan Kumarasamy, researchers set out to determine how common the NDM-1-carrying bacteria were in South Asia and Britain, where several cases had turned up.
Checking hospital patients with suspected symptoms, they found 44 cases -- 1.5 percent of those screened -- in Chennai, and 26 (eight percent of those screened) in Haryana, both in India.
They likewise found the superbug in Bangladesh and Pakistan, as well as 37 cases in Britain, some in patients who had recently returned from having cosmetic surgery in India or Pakistan
Anil Chadha, a senior plastic surgeon in the west Indian city of Ahmedabad, said the way the study had been reported in the media was bound to scare off some foreigners.
"People will think twice before coming to India for a treatment. I think the reports are economically motivated to prevent patients coming here," Chadha told AFP.
Another plastic surgeon, K.M Kapoor, based in the northern city of Mohali, agreed that the study was being used to "malign" India's health system.
"And naming the bug after New Delhi is simply ridiculous," he added.
